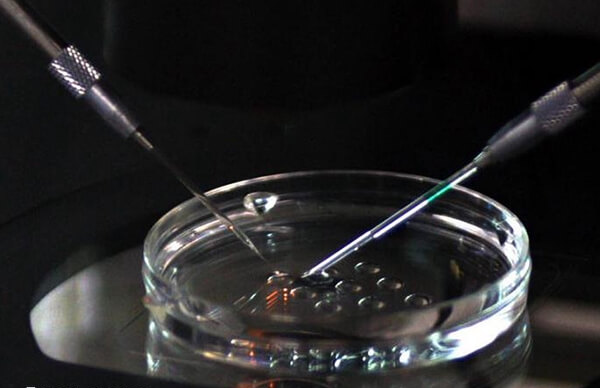
山大生殖取卵手术费用在一万左右

在山大生殖医院做试管婴儿,取卵前要交多少钱?
发布:2025-10-31 19:00:20
浏览183次
问题描述:
正常来讲,在山大生殖进行试管婴儿,取卵的手术费用大概在一万元左右,但是因为卵子取出来之后,与精子结合形成多个胚胎,医生会选择一些进行移植,还有一些会进行保存,所以这里冷冻胚胎还需要一定的费用。而手术取卵部分的费用,每个手术患者不会有太大差别。
最佳答案
正常来讲,在山大生殖进行试管婴儿,取卵的手术费用大概在一万元左右,但是因为卵子取出来之后,与精子结合形成多个胚胎,医生会选择一些进行移植,还有一些会进行保存,所以这里冷冻胚胎还需要一定的费用。而手术取卵部分的费用,每个手术患者不会有太大差别。
山大生殖医院试管婴儿费用
山大生殖医院试管婴儿费用除了取卵手术费外还包含试管婴儿促排卵费用,前期后期检查费用,试管婴儿移植费用,胚胎冷冻费用等,整体费用也不贵,一次成功5-6万。基本上都会按照标准进行收费的,所以基本上不会出现乱收费的情况。
- 因为取卵属于有创操作,对女性的卵巢会造成一定程度的伤害,所以建议取卵后休息一周的时间;
- 取卵以后休息时间与取卵的个数,以及个人的身体素质是有关系的;
- 如果取卵比较多的话,一般会发生下腹部疼痛,甚至腹水,腹胀,食欲不振等情况,这时建议休息10天到半个月的时间;
- 要增加饮食营养,保持营养均衡,不要吃辛辣等刺激性食物。
同时还要注意,取卵后基本上要不了几天就会进行试管的移植,这段时间内,一定不能同房,因为可能会影响胚胎的着床,从而降低试管移植的成功率。
好孕交流群 分享心理 链接关系 共同目标
最新问题
- 青岛妇幼保健院人工授精哪个医生好?附4大生殖专家推荐 2026-06-25
- 郑州大学第二附属医院做试管婴儿准备5万够吗? 2026-06-25
- 山东省妇幼保健院试管婴儿成功率怎么样?能达到50%吗? 2026-06-24
- 济宁医学院附属医院生殖科医生哪位好?做试管婴儿找谁? 2026-06-24
- 滨州试管婴儿费用大约多少?准备3万元够吗? 2026-06-23
- 郑州三代试管婴儿医院哪个好?郑大三附院怎么样? 2026-06-23
热点问题榜
网友关注的问题
排名
主题
阅读量
-
13828 -
212754
-
312573
-
411571
-
511522
-
611331
-
711148
-
811003
-
910917
-
1010328
热门资讯
助您好孕多多
医院




